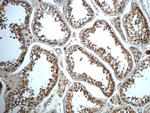
ALDH1B1 Antibody in Immunohistochemistry (Paraffin) (IHC (P))
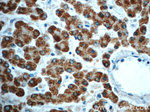
ALDH1B1 Antibody in Immunohistochemistry (Paraffin) (IHC (P))

Search
Proteintech
ALDH1B1 Polyclonal Antibody
{{$productOrderCtrl.translations['antibody.pdp.commerceCard.promotion.promotions']}}
{{$productOrderCtrl.translations['antibody.pdp.commerceCard.promotion.viewpromo']}}
{{$productOrderCtrl.translations['antibody.pdp.commerceCard.promotion.promocode']}}: {{promo.promoCode}} {{promo.promoTitle}} {{promo.promoDescription}}. {{$productOrderCtrl.translations['antibody.pdp.commerceCard.promotion.learnmore']}}
产品信息
22220-1-AP
种属反应
已发表种属
宿主/亚型
分类
类型
抗原
偶联物
形式
浓度
规格
纯化类型
保存液
内含物
保存条件
运输条件
产品详细信息
This antibody is specific to ALDH1B1.
Immunogen sequence: SIYNEFLER TVEKAKQRKV GNPFELDTQQ GPQVDKEQFE RVLGYIQLGQ KEGA (330-382 aa encoded by B C001619)
靶标信息
Aldehyde dehydrogenases (ALDHs) mediate NADP+-dependent oxidation of aldehydes into acids during detoxification of alcohol-derived acetaldehyde, lipid peroxidation and metabolism of corticosteroids, biogenic amines and neurotransmitters. Alcohol drinking habits and cardiovascular disease risk factors may be associated with ALDH gene variants. ALDH1B1 (Aldehyde dehydrogenase family 1 member B1), also known as ALDH5 or ALDHX (Aldehyde dehydrogenase X, mitochondrial), is a 517 amino acid mitochondrial protein that is expressed in the liver, testis and to a lesser extent in brain. ALDH1B1 belongs to the aldehyde dehydrogenase family and may play a major role in ethanol detoxification.
仅用于科研。不用于诊断过程。未经明确授权不得转售。
生物信息学
蛋白别名: acetaldehyde dehydrogenase 5; aldehyde dehydrogenase 1B1; Aldehyde dehydrogenase 5; Aldehyde dehydrogenase family 1 member B1; Aldehyde dehydrogenase X, mitochondrial; ALDH class 2; epididymis secretory sperm binding protein; MGC2230; unnamed protein product
基因别名: 2700007F14Rik; ALDH1B1; ALDH5; ALDHX
UniProt ID: (Human) P30837, (Mouse) Q9CZS1, (Rat) Q66HF8
Entrez Gene ID: (Human) 219, (Mouse) 72535, (Rat) 298079